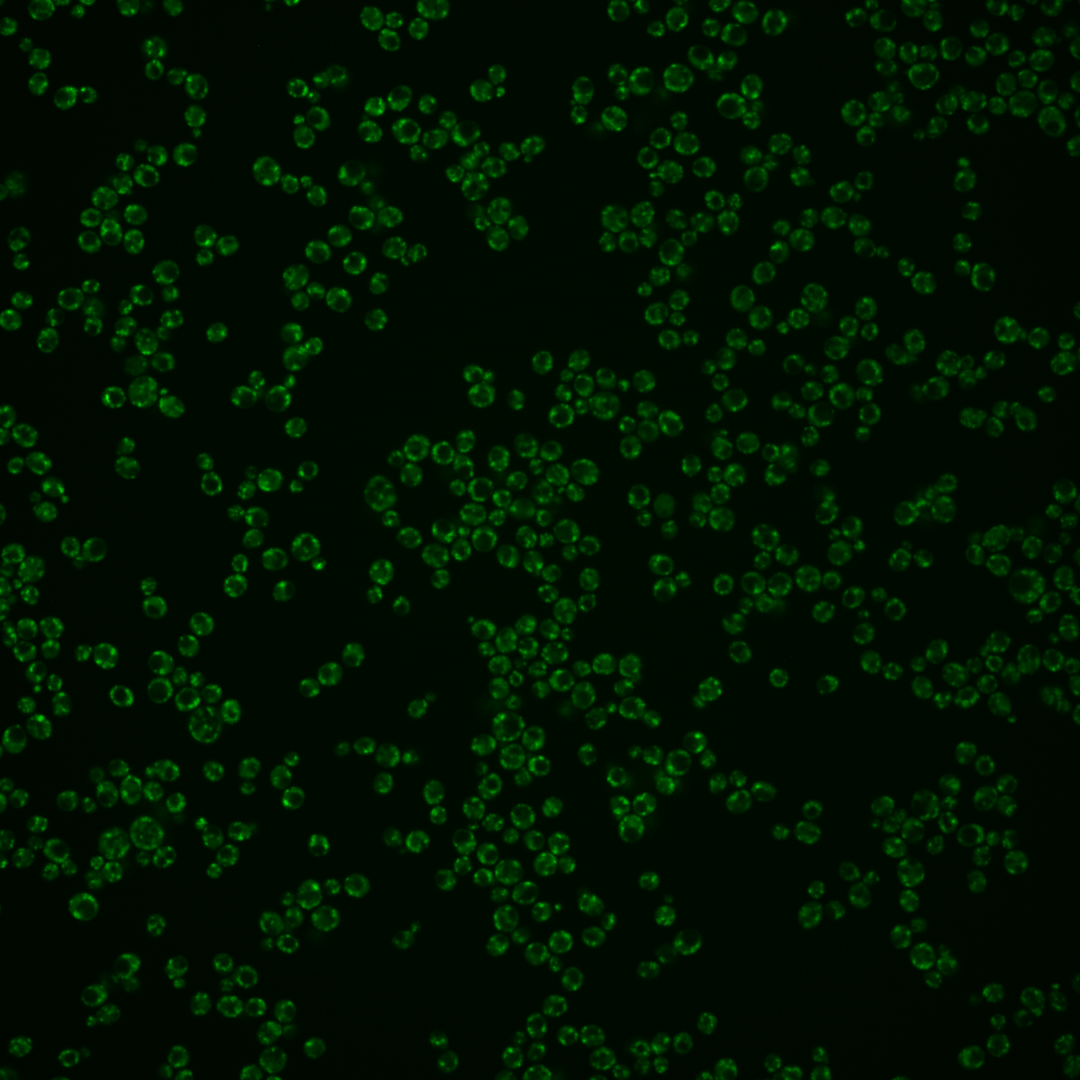
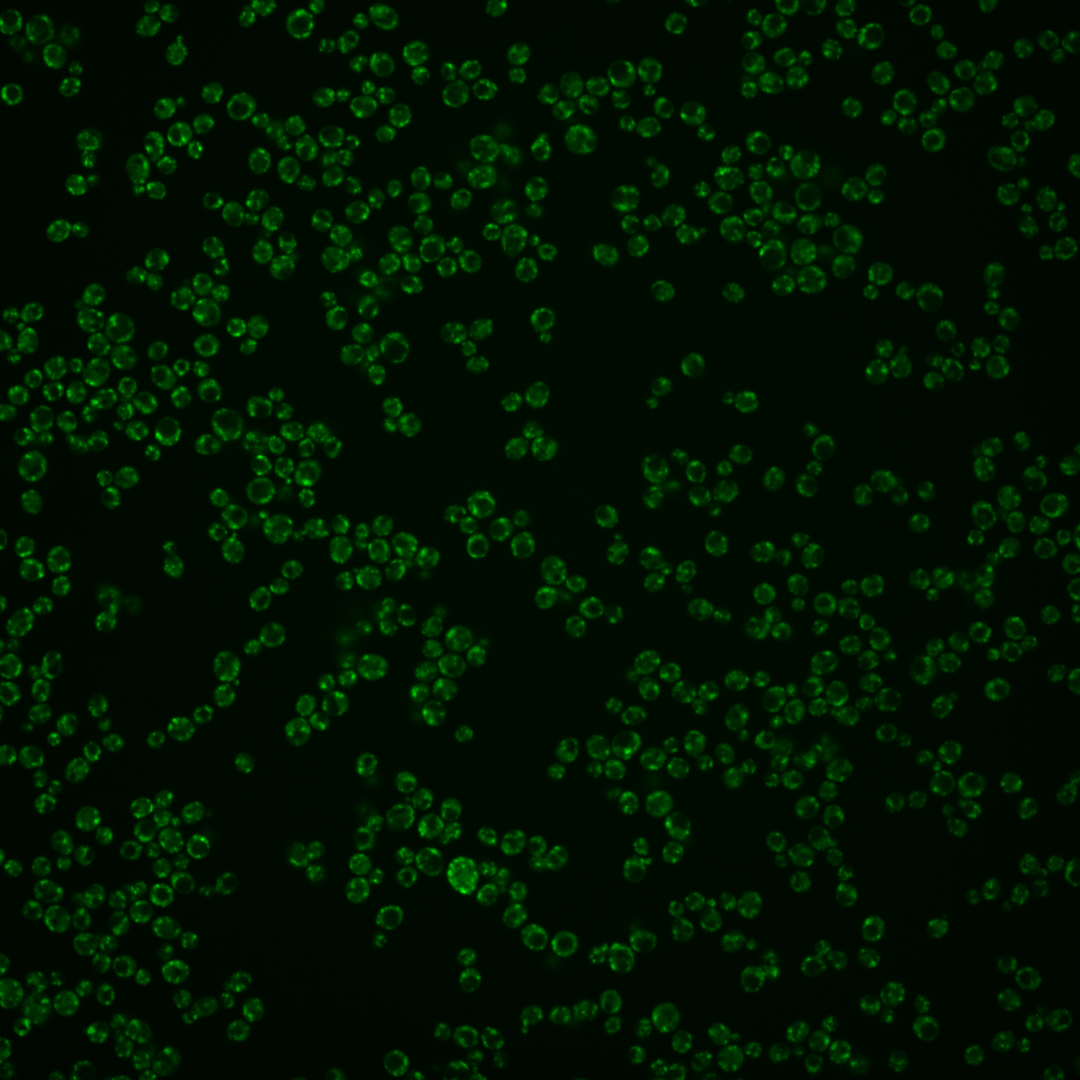
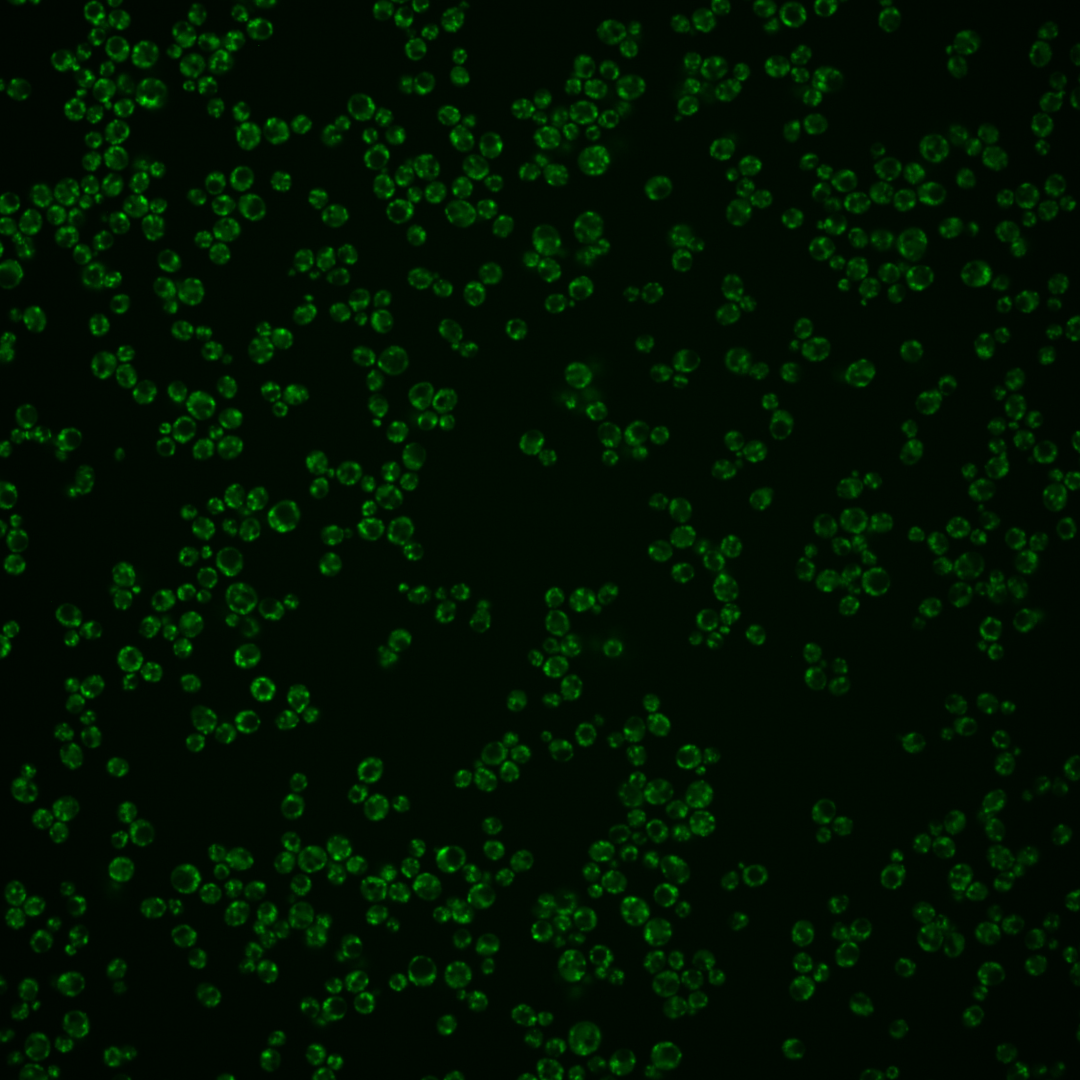

| Standard name | |
|---|---|
| Human Ortholog | |
| Description | ADP-ribosylation factor GTPase activating protein (ARF GAP); involved in ER-Golgi transport; shares functional similarity with Gcs1p |
Micrographs




















































































Sub-cellular Localization
Yeast GFP Assignment
Protein Abundance
Localization Change
External localization resources
| ensLOC | DeepLoc | |||||||||||||||||||||||
|---|---|---|---|---|---|---|---|---|---|---|---|---|---|---|---|---|---|---|---|---|---|---|---|---|
| Localization | WT1 | WT2 | WT3 | RAP60 | RAP140 | RAP220 | RAP300 | RAP380 | RAP460 | RAP540 | RAP620 | RAP700 | HU80 | HU120 | HU160 | rpd3Δ_1 | rpd3Δ_2 | rpd3Δ_3 | WT1 | WT2 | WT3 | AF100 | AF140 | AF180 |
| Cortical Patches | 8 | 54 | 7 | 0 | 1 | 5 | 0 | 4 | 6 | 2 | 2 | 3 | 15 | 14 | 4 | 31 | 23 | 20 | 2 | 6 | 5 | 3 | 8 | 14 |
| Bud | 3 | 0 | 1 | 1 | 0 | 0 | 0 | 4 | 3 | 3 | 3 | 6 | 1 | 4 | 3 | 0 | 1 | 1 | 0 | 1 | 2 | 0 | 3 | 1 |
| Bud Neck | 0 | 0 | 0 | 0 | 0 | 0 | 0 | 0 | 0 | 0 | 0 | 0 | 0 | 0 | 0 | 0 | 0 | 0 | 0 | 0 | 0 | 0 | 0 | 0 |
| Bud Site | 0 | 0 | 0 | 0 | 0 | 0 | 0 | 0 | 2 | 0 | 0 | 2 | 0 | 0 | 0 | 1 | 0 | 0 | – | – | – | – | – | – |
| Cell Periphery | 0 | 1 | 0 | 0 | 0 | 0 | 0 | 2 | 3 | 2 | 0 | 5 | 0 | 1 | 2 | 2 | 2 | 2 | 0 | 0 | 0 | 0 | 0 | 0 |
| Cytoplasm | 2 | 25 | 8 | 8 | 14 | 8 | 9 | 6 | 12 | 6 | 7 | 4 | 6 | 9 | 16 | 15 | 16 | 10 | 1 | 4 | 1 | 0 | 1 | 0 |
| Endoplasmic Reticulum | 4 | 41 | 9 | 5 | 1 | 10 | 8 | 10 | 13 | 3 | 6 | 10 | 22 | 13 | 15 | 6 | 7 | 9 | 1 | 3 | 1 | 1 | 2 | 4 |
| Endosome | 0 | 0 | 1 | 0 | 1 | 0 | 1 | 0 | 0 | 0 | 0 | 0 | 3 | 3 | 2 | 10 | 4 | 0 | 7 | 7 | 10 | 4 | 4 | 8 |
| Golgi | 60 | 242 | 65 | 17 | 25 | 11 | 6 | 12 | 7 | 8 | 5 | 5 | 266 | 194 | 237 | 237 | 223 | 168 | 134 | 275 | 137 | 190 | 276 | 218 |
| Mitochondria | 115 | 119 | 126 | 84 | 81 | 172 | 175 | 253 | 166 | 176 | 172 | 220 | 195 | 158 | 150 | 30 | 27 | 16 | 4 | 11 | 8 | 5 | 7 | 6 |
| Nucleus | 0 | 0 | 0 | 0 | 1 | 1 | 0 | 1 | 0 | 3 | 0 | 0 | 1 | 0 | 2 | 2 | 3 | 0 | 0 | 0 | 0 | 1 | 0 | 0 |
| Nuclear Periphery | 0 | 0 | 0 | 0 | 1 | 1 | 3 | 3 | 3 | 2 | 4 | 3 | 0 | 0 | 0 | 2 | 2 | 0 | 0 | 0 | 0 | 1 | 0 | 0 |
| Nucleolus | 3 | 3 | 3 | 4 | 2 | 4 | 6 | 12 | 6 | 6 | 5 | 5 | 4 | 0 | 3 | 7 | 4 | 1 | 0 | 0 | 0 | 0 | 0 | 0 |
| Peroxisomes | 0 | 0 | 0 | 0 | 0 | 1 | 0 | 0 | 0 | 1 | 0 | 0 | 0 | 0 | 0 | 0 | 0 | 0 | 0 | 0 | 1 | 0 | 0 | 0 |
| SpindlePole | 0 | 0 | 0 | 0 | 0 | 0 | 0 | 0 | 1 | 0 | 0 | 0 | 0 | 0 | 0 | 0 | 0 | 0 | 0 | 1 | 0 | 0 | 0 | 0 |
| Vac/Vac Membrane | 24 | 39 | 9 | 8 | 13 | 8 | 9 | 21 | 4 | 10 | 5 | 4 | 38 | 38 | 47 | 60 | 39 | 31 | 5 | 38 | 2 | 3 | 5 | 6 |
| Unique Cell Count | 138 | 333 | 155 | 99 | 112 | 189 | 193 | 277 | 185 | 196 | 185 | 231 | 348 | 289 | 349 | 313 | 251 | 190 | 158 | 354 | 174 | 214 | 311 | 268 |
| Labelled Cell Count | 219 | 524 | 229 | 127 | 140 | 221 | 217 | 328 | 226 | 222 | 209 | 267 | 551 | 434 | 481 | 403 | 351 | 258 | 158 | 354 | 174 | 214 | 311 | 268 |
Yeast GFP Assignment
Protein Abundance
| Screen | WT1 | WT2 | WT3 | RAP60 | RAP140 | RAP220 | RAP300 | RAP380 | RAP460 | RAP540 | RAP620 | RAP700 | HU80 | HU120 | HU160 | rpd3Δ_1 | rpd3Δ_2 | rpd3Δ_3 | AF100 | AF140 | AF180 |
|---|---|---|---|---|---|---|---|---|---|---|---|---|---|---|---|---|---|---|---|---|---|
| Mean Cell GFP Intensity (1e-4) | 15.7 | 20.1 | 13.0 | 11.2 | 11.6 | 11.2 | 9.3 | 9.4 | 9.6 | 9.4 | 9.2 | 9.0 | 16.8 | 16.1 | 16.4 | 17.2 | 22.3 | 23.2 | 14.6 | 14.6 | 14.7 |
| Std Deviation (1e-4) | 2.4 | 3.5 | 3.0 | 2.9 | 2.7 | 2.7 | 2.1 | 2.3 | 2.2 | 2.1 | 2.1 | 2.2 | 3.1 | 3.6 | 3.6 | 5.0 | 6.2 | 5.8 | 3.0 | 2.3 | 2.6 |
| Intensity Change (Log2) | – | – | – | -0.22 | -0.17 | -0.22 | -0.48 | -0.47 | -0.44 | -0.47 | -0.5 | -0.54 | 0.37 | 0.31 | 0.33 | 0.4 | 0.78 | 0.83 | 0.17 | 0.16 | 0.17 |
Localization Change
| Localization | RAP60 | RAP140 | RAP220 | RAP300 | RAP380 | RAP460 | RAP540 | RAP620 | RAP700 | HU80 | HU120 | HU160 | rpd3Δ_1 | rpd3Δ_2 | rpd3Δ_3 |
|---|---|---|---|---|---|---|---|---|---|---|---|---|---|---|---|
| Cortical Patches | 0 | 0 | -0.9 | 0 | 0 | -0.6 | 0 | 0 | 0 | -0.1 | 0.2 | 0 | 2.0 | 1.7 | 2.1 |
| Bud | 0 | 0 | 0 | 0 | 0 | 0 | 0 | 0 | 0 | 0 | 0 | 0 | 0 | 0 | 0 |
| Bud Neck | 0 | 0 | 0 | 0 | 0 | 0 | 0 | 0 | 0 | 0 | 0 | 0 | 0 | 0 | 0 |
| Bud Site | 0 | 0 | 0 | 0 | 0 | 0 | 0 | 0 | 0 | 0 | 0 | 0 | 0 | 0 | 0 |
| Cell Periphery | 0 | 0 | 0 | 0 | 0 | 0 | 0 | 0 | 0 | 0 | 0 | 0 | 0 | 0 | 0 |
| Cytoplasm | 0.9 | 2.2 | -0.4 | -0.2 | -1.7 | 0.5 | -1.0 | -0.6 | 0 | 0 | -1.1 | -0.3 | -0.2 | 0.5 | 0 |
| Endoplasmic Reticulum | -0.3 | 0 | -0.2 | -0.7 | -1.1 | 0.5 | -2.2 | -1.1 | -0.7 | 0.2 | -0.6 | -0.7 | 0 | -1.5 | -0.4 |
| Endosome | 0 | 0 | 0 | 0 | 0 | 0 | 0 | 0 | 0 | 0 | 0 | 0 | 0 | 0 | 0 |
| Golgi | -4.1 | -3.3 | -8.0 | -8.9 | -9.8 | -8.6 | -8.7 | -8.9 | -9.9 | 7.5 | 5.1 | 5.5 | 7.2 | 10.1 | 9.2 |
| Mitochondria | 0.7 | -1.7 | 2.6 | 2.5 | 3.1 | 2.2 | 2.3 | 3.3 | 4.4 | -5.4 | -5.6 | -8.0 | -15.5 | -14.2 | -13.7 |
| Nucleus | 0 | 0 | 0 | 0 | 0 | 0 | 0 | 0 | 0 | 0 | 0 | 0 | 0 | 0 | 0 |
| Nuclear Periphery | 0 | 0 | 0 | 0 | 0 | 0 | 0 | 0 | 0 | 0 | 0 | 0 | 0 | 0 | 0 |
| Nucleolus | 0 | 0 | 0 | 0 | 1.3 | 0 | 0 | 0 | 0 | 0 | 0 | 0 | 0 | 0 | 0 |
| Peroxisomes | 0 | 0 | 0 | 0 | 0 | 0 | 0 | 0 | 0 | 0 | 0 | 0 | 0 | 0 | 0 |
| SpindlePole | 0 | 0 | 0 | 0 | 0 | 0 | 0 | 0 | 0 | 0 | 0 | 0 | 0 | 0 | 0 |
| Vacuole | 0.7 | 1.7 | -0.7 | -0.5 | 0.7 | -1.7 | -0.3 | -1.4 | -2.2 | 1.8 | 2.4 | 2.5 | 3.8 | 3.0 | 3.0 |
External localization resources
Images






























Protein Concentration and Protein Localization Data
| R1 | R2 | R3 | ||||||||||||||||
|---|---|---|---|---|---|---|---|---|---|---|---|---|---|---|---|---|---|---|
| G1 Pre-START | G1 Post-START | S/G2 | Metaphase | Anaphase | Telophase | G1 Pre-START | G1 Post-START | S/G2 | Metaphase | Anaphase | Telophase | G1 Pre-START | G1 Post-START | S/G2 | Metaphase | Anaphase | Telophase | |
| Concentration | 20.3041 | 22.1351 | 21.1867 | 21.2803 | 21.072 | 20.912 | 16.6525 | 19.0228 | 18.403 | 18.9213 | 17.201 | 18.0947 | 20.7849 | 21.9109 | 21.4243 | 21.687 | 21.3409 | 21.2052 |
| Actin | 0.0018 | 0.0009 | 0.0006 | 0.0014 | 0.0004 | 0.0023 | 0.0233 | 0.0042 | 0.0175 | 0.0098 | 0.0054 | 0.0046 | 0.0055 | 0.0017 | 0.0071 | 0.0064 | 0.0121 | 0.0014 |
| Bud | 0.0001 | 0 | 0.0001 | 0.0002 | 0 | 0 | 0.0003 | 0.0001 | 0.0003 | 0.0001 | 0.0001 | 0.0001 | 0.0003 | 0.0001 | 0.0006 | 0.0004 | 0.0003 | 0.0001 |
| Bud Neck | 0.0001 | 0.0001 | 0.0001 | 0.0001 | 0.0001 | 0.0001 | 0.0003 | 0.0001 | 0.0001 | 0.0001 | 0.0001 | 0.0001 | 0.0002 | 0.0001 | 0.0001 | 0.0001 | 0.0002 | 0.0001 |
| Bud Periphery | 0.0001 | 0 | 0 | 0.0003 | 0.0001 | 0.0001 | 0.0003 | 0.0001 | 0.0003 | 0.0001 | 0.0001 | 0.0001 | 0.0003 | 0.0001 | 0.0007 | 0.0014 | 0.0006 | 0.0001 |
| Bud Site | 0.0003 | 0.0001 | 0 | 0.0001 | 0 | 0 | 0.0007 | 0.0001 | 0.0002 | 0.0002 | 0.0002 | 0.0001 | 0.0005 | 0.0001 | 0.0003 | 0.0002 | 0.0002 | 0 |
| Cell Periphery | 0.0002 | 0.0001 | 0 | 0.0001 | 0 | 0 | 0.0001 | 0 | 0.0001 | 0 | 0.0001 | 0 | 0.0001 | 0.0001 | 0.0001 | 0.0008 | 0.0002 | 0 |
| Cytoplasm | 0.0008 | 0.0018 | 0.0009 | 0.0004 | 0.0005 | 0.0004 | 0.0069 | 0.0026 | 0.0028 | 0.0008 | 0.0006 | 0.0005 | 0.0013 | 0.002 | 0.0013 | 0.0011 | 0.0007 | 0.0007 |
| Cytoplasmic Foci | 0.0117 | 0.0194 | 0.0118 | 0.0091 | 0.0095 | 0.0074 | 0.0216 | 0.024 | 0.017 | 0.0151 | 0.0165 | 0.0095 | 0.0121 | 0.0223 | 0.0143 | 0.0139 | 0.0131 | 0.0102 |
| Eisosomes | 0 | 0 | 0 | 0.0001 | 0 | 0.0001 | 0.0002 | 0 | 0.0001 | 0.0001 | 0 | 0 | 0.0001 | 0 | 0 | 0 | 0.0001 | 0 |
| Endoplasmic Reticulum | 0.0007 | 0.0007 | 0.0007 | 0.0007 | 0.0007 | 0.0007 | 0.0027 | 0.0009 | 0.0023 | 0.0006 | 0.0009 | 0.0004 | 0.001 | 0.0008 | 0.0008 | 0.0014 | 0.0009 | 0.0007 |
| Endosome | 0.1194 | 0.1598 | 0.1299 | 0.0891 | 0.0998 | 0.0738 | 0.1161 | 0.1465 | 0.1163 | 0.125 | 0.1288 | 0.0699 | 0.1395 | 0.1731 | 0.157 | 0.2251 | 0.1893 | 0.0955 |
| Golgi | 0.7982 | 0.7645 | 0.7922 | 0.8321 | 0.8522 | 0.8708 | 0.7336 | 0.7883 | 0.8125 | 0.7915 | 0.7842 | 0.8799 | 0.7401 | 0.7684 | 0.7728 | 0.6866 | 0.7654 | 0.8608 |
| Lipid Particles | 0.004 | 0.0013 | 0.0005 | 0.0011 | 0.0006 | 0.0014 | 0.0043 | 0.0008 | 0.001 | 0.0005 | 0.0143 | 0.0003 | 0.0051 | 0.001 | 0.0015 | 0.0025 | 0.0029 | 0.0009 |
| Mitochondria | 0.0528 | 0.0415 | 0.0494 | 0.0445 | 0.0318 | 0.0342 | 0.0703 | 0.0214 | 0.0184 | 0.0129 | 0.0139 | 0.0323 | 0.0794 | 0.0199 | 0.0247 | 0.023 | 0.0047 | 0.0235 |
| None | 0 | 0 | 0 | 0 | 0 | 0 | 0.0032 | 0 | 0.0004 | 0 | 0 | 0 | 0 | 0 | 0.0001 | 0.0001 | 0 | 0 |
| Nuclear Periphery | 0.0001 | 0.0001 | 0.0002 | 0.0003 | 0.0001 | 0.0004 | 0.0027 | 0.0003 | 0.0003 | 0.0004 | 0.0004 | 0 | 0.0003 | 0.0001 | 0.0003 | 0.001 | 0.0005 | 0.0001 |
| Nucleolus | 0.0002 | 0 | 0 | 0 | 0 | 0 | 0.0002 | 0 | 0 | 0 | 0 | 0 | 0 | 0 | 0.0001 | 0.0001 | 0 | 0 |
| Nucleus | 0.0001 | 0 | 0 | 0.0001 | 0 | 0 | 0.0028 | 0.0001 | 0.0001 | 0 | 0 | 0 | 0.0001 | 0 | 0.0001 | 0.0002 | 0 | 0 |
| Peroxisomes | 0.0003 | 0.0001 | 0.0001 | 0.0001 | 0.0001 | 0 | 0.0026 | 0.0004 | 0.001 | 0.0002 | 0.023 | 0.0003 | 0.0002 | 0.0002 | 0.0004 | 0.0001 | 0.0001 | 0.0001 |
| Punctate Nuclear | 0 | 0 | 0 | 0 | 0 | 0 | 0.0015 | 0 | 0.0002 | 0 | 0.0001 | 0 | 0 | 0 | 0.0001 | 0 | 0 | 0 |
| Vacuole | 0.0038 | 0.004 | 0.0038 | 0.0085 | 0.001 | 0.0027 | 0.0019 | 0.0046 | 0.0039 | 0.0137 | 0.0019 | 0.0005 | 0.0044 | 0.003 | 0.0076 | 0.0149 | 0.0023 | 0.0015 |
| Vacuole Periphery | 0.0051 | 0.0054 | 0.0098 | 0.0118 | 0.003 | 0.0054 | 0.0043 | 0.0054 | 0.0053 | 0.0288 | 0.0092 | 0.0015 | 0.0094 | 0.007 | 0.0098 | 0.0208 | 0.0064 | 0.0042 |
Sequencing Data
| R1 | R2 | |||||||||
|---|---|---|---|---|---|---|---|---|---|---|
| G1 Post-START | S/G2 | Metaphase | Anaphase | Telophase | G1 Post-START | S/G2 | Metaphase | Anaphase | Telophase | |
| Gene Expression | 92.3226 | 85.1931 | 47.9066 | 69.0975 | 76.2607 | 64.7389 | 86.3069 | 82.8918 | 70.6526 | 84.4312 |
| Translational Efficiency | 2.3591 | 2.6349 | 2.8661 | 1.5257 | 2.1777 | 3.0537 | 1.9535 | 1.577 | 1.8041 | 1.8601 |
Hit Data
| Dataset | Hit |
|---|---|
| Protein Concentration | ✔ |
| Protein Localization | ✘ |
| Gene Expression | ✘ |
| Translational Efficiency | ✘ |
Endocytosis
| Temp | Actin Patch (Sac6-tdTomato) | Cortical Patch (Sla1-GFP) | Late Endosome (Snf7-GFP) | Vacuole (Vph1-GFP) |
|---|---|---|---|---|
| 37℃ | ||||
| RT |
Cell Cycle Omics
CYCLoPs (Glo3-GFP)
| Gene / Allele | Actin Patch (Sac6-tdTomato) | Cortical Patch (Sla1-GFP) | Late Endosome (Snf7-GFP) | Vacuole (Sac6-tdTomato) |
|---|
| Gene | Images |
|---|
| Gene | Images |
|---|
Images are not yet available
Images are not yet available